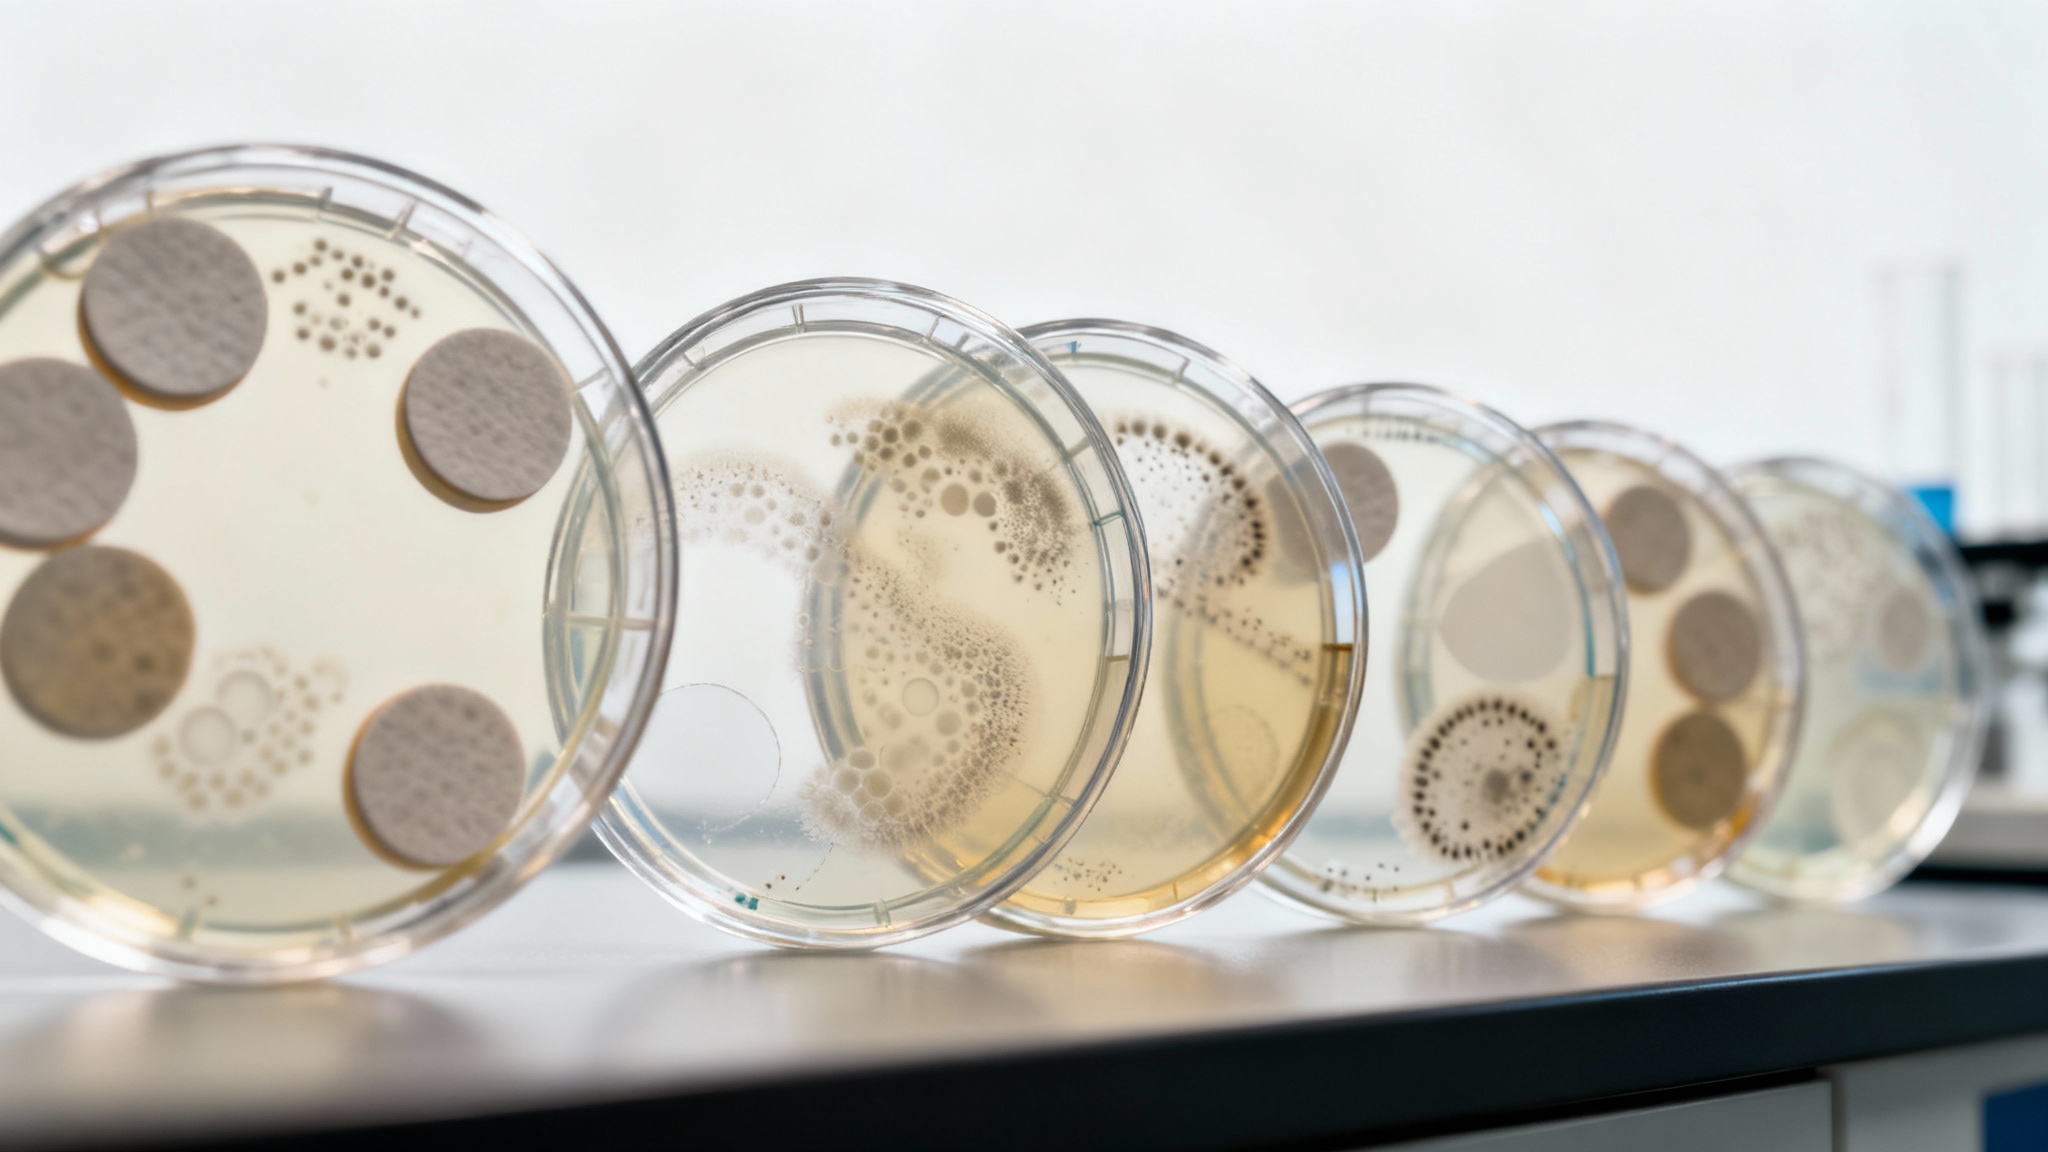

Un écosystème complexe sous la mousse

Ce milieu est en effet l’un des habitats microbiens les plus densément peuplés du corps, abritant allègrement plus de 700 espèces différentes de bactéries. Ces microorganismes vivent en communautés structurées, appelées « biofilms », sur les dents et les gencives, mais prospèrent également dans notre salive, faisant de notre bouche un environnement dynamique et jamais figé.
La dysbiose, quand l’équilibre tourne mal

Lorsque les bactéries nuisibles prennent le dessus, on parle de dysbiose. Ce déséquilibre n’est pas seulement synonyme de risques accrus de caries ou de maladies des gencives. Des résultats de recherches récents révèlent son importance pour notre santé générale, l’inflammation déclenchée par les bactéries buccales pouvant potentiellement contribuer à des problèmes de santé systémiques, allant des maladies cardiaques au diabète.
Le rôle caché du dentifrice : l’art de la perturbation

Le fluor, souvent au centre de la conversation, ne tue pas directement les bactéries. Il agit plutôt comme un bouclier, renforçant l’émail des dents. Il limite ainsi l’opportunité de dégâts pour les bactéries productrices d’acides, comme la redoutée Streptococcus mutans, grande coupable des caries.
L’épineuse question des agents antibactériens
Les recherches pour comprendre l’impact du dentifrice sur ce vaste écosystème sont toujours en cours et les conclusions divergent. Si certaines études suggèrent qu’une perturbation large affecte aussi bien les bonnes que les mauvaises bactéries, d’autres résultats indiquent que le microbiote est étonnamment résilient et qu’il se rétablit très rapidement après le brossage. La perturbation serait donc temporaire.
Vers un dentifrice plus « respectueux » du microbiote

Parmi les candidats prometteurs figurent l’arginine, un acide aminé naturel qui favoriserait la croissance des bonnes bactéries, et certains antimicrobiens d’origine végétale. L’idée est de s’éloigner des antibactériens à large spectre pour adopter une approche ciblée et subtile.
L’avenir des probiotiques dans notre bouche

Cependant, ce domaine en est encore à ses balbutiements. Il faudra recueillir davantage de preuves pour déterminer quels peuvent être les effets à long terme de ces ingrédients sur notre équilibre buccal complexe.
Le geste mécanique reste maître

En attendant le dentifrice du futur, le secret est donc de se brosser les dents avec une pâte fluorée deux fois par jour et, de façon cruciale, de procéder à un nettoyage régulier des espaces interdentaires, que ce soit avec du fil ou des brossettes. C’est l’action physique et régulière qui continue de faire la plus grande différence.